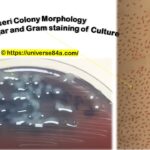
Citrobacter koseri- Introduction, Morphology, Pathogenicity, Lab Diagnosis, Treatment, Prevention, and Keynotes

Tag: Citrobacter koseri
Citrobacter koseri: Introduction, Morphology, Pathogenicity, Lab Diagnosis, Treatment, Prevention, and Keynotes
Introduction Citrobacter koseri, formerly known as Citrobacter diversus, is a...
Introduction Citrobacter koseri, formerly known as Citrobacter diversus, is a...
Common Bacteria Biochemical Test Demonstration: Introduction, Common Tests and List of Organisms
 Introduction of Common Bacteria Biochemical Test Demonstration 'Common Bacterial Biochemical...
Introduction of Common Bacteria Biochemical Test Demonstration 'Common Bacterial Biochemical...
